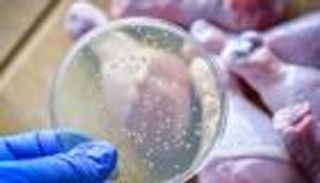
فيروس وفضة.. فريق بحثي يطور حلا مبتكرا للبكتيريا الخطيرة (خاص)

انتشار فيروس غامض في غزة.. ومصادر طبية: لا أحد يعرف سببه

يشهد قطاع غزة تفشي فيروس مجهول السبب في ظل انعدام الإمكانات الطبية اللازمة لتشخيصه، فيما تتواصل تصريحات إسرائيلية تدعو إلى تشديد الحصار على السكان.
أكد مدير مجمع الشفاء الطبي في قطاع غزة، أن الفيروس ينتشر بين السكان دون أن تتوفر أي أدوات أو تقنيات تمكن من تحديد مسبباته. وأوضح أن الوضع الصحي يزداد تعقيدًا نتيجة سوء التغذية الذي يعانيه الأهالي، وهو ما يضعف المناعة لديهم، إضافة إلى غياب مصادر المياه النظيفة.
وفي السياق نفسه، أدلى وزير المالية الإسرائيلي بتسلئيل سموتريتش بتصريحات دعي فيها إسرائيل إلى قطع المياه والكهرباء والطعام عن قطاع غزة، زاعمًا أن من لا يلقى حتفه بالرصاص سيواجه خطر الموت جوعًا. وأضاف أن الهدف الأساسي من الإجراءات الإسرائيلية هو تقويض ما وصفه بمراكز الثقل العسكري التابعة لحركة حماس وصولًا إلى نزع سلاحها.
وأشار سموتريتش إلى أن "مشكلة سكان غزة يمكن حلها إذا فُتحت أمامهم أبواب الهجرة الطوعية"، مؤكدًا في الوقت نفسه أن إسرائيل لن تقبل بأي صفقات ما دامت الحركة قادرة على إعادة تنظيم صفوفها، متوعدًا بإنذار يحمل خيارين لا ثالث لهما: إما الحرب أو الاستسلام.
كما أوضح الوزير الإسرائيلي أن الخطة العسكرية تتضمن السيطرة التدريجية على أجزاء من غزة، قائلاً: "كل أسبوع نضم جزءًا، وبعد مرور شهر ستكون معظم المناطق تحت السيطرة الإسرائيلية". ولفت إلى أن القرار النهائي بشأن القطاع ينبغي أن يتخذه المجلس الوزاري الأمني المصغر، على أن يتولى الجيش مهمة التنفيذ المباشر.